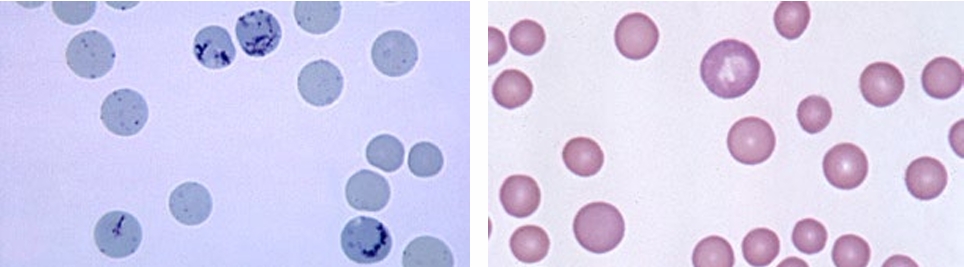
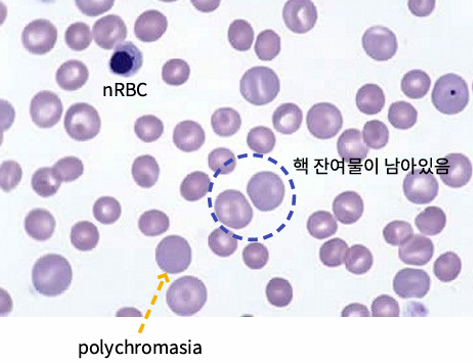
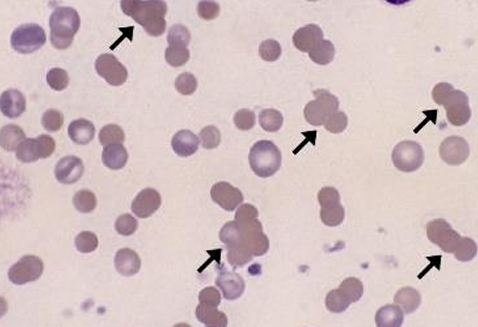
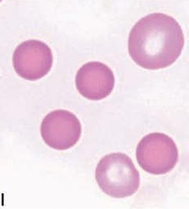
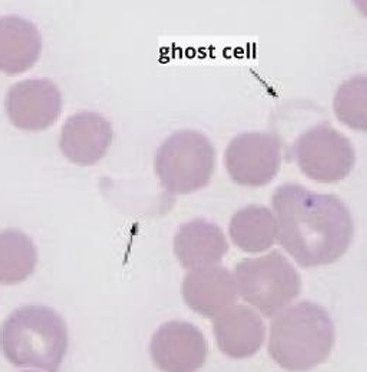
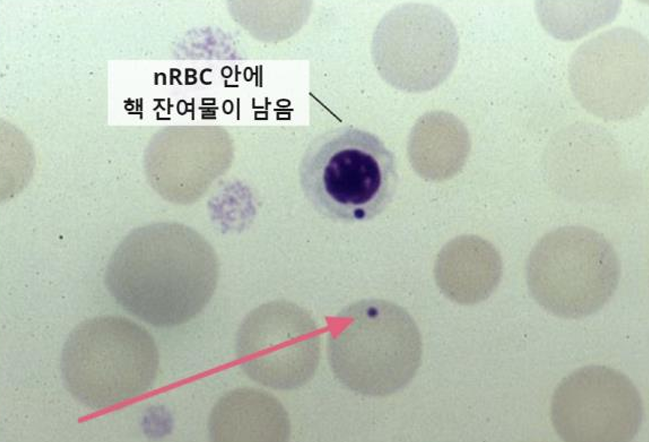
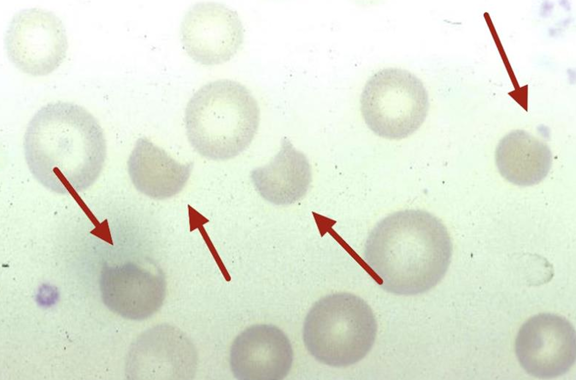
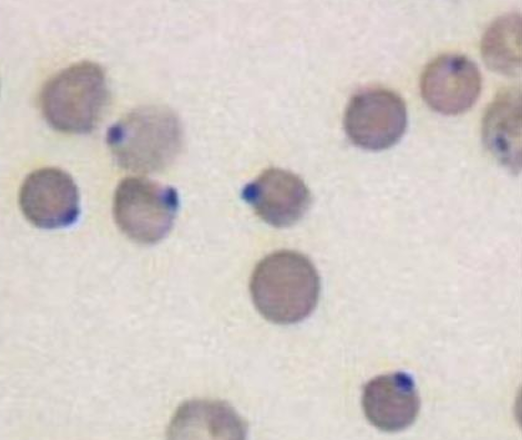
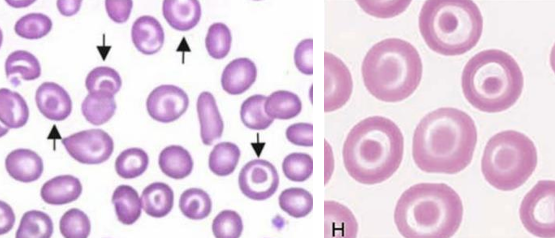
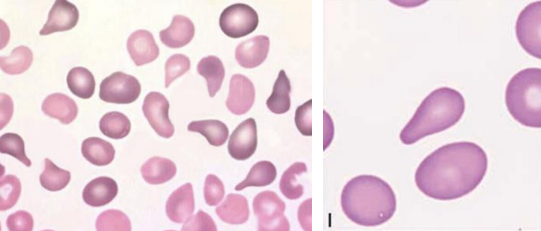
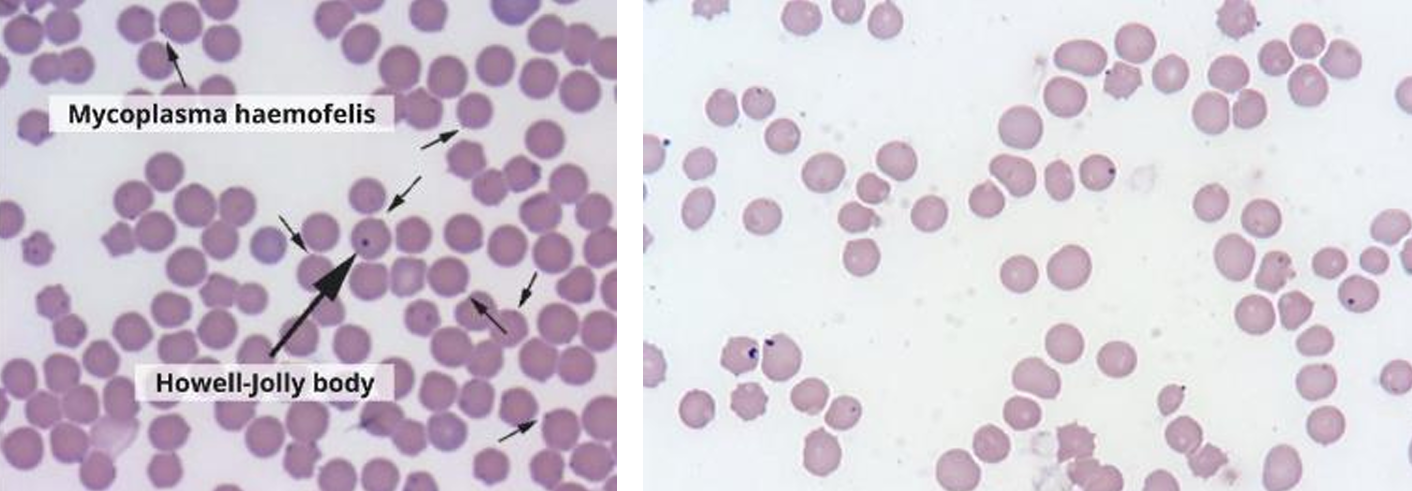
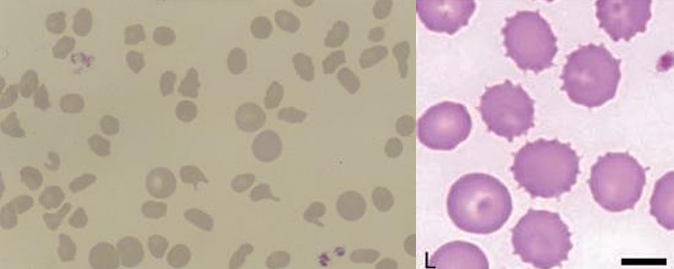
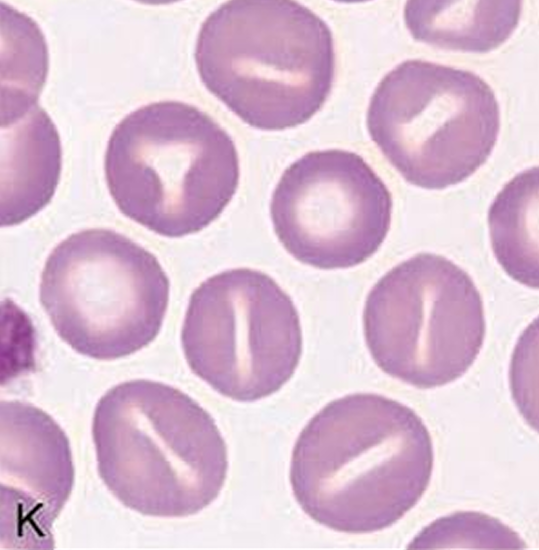
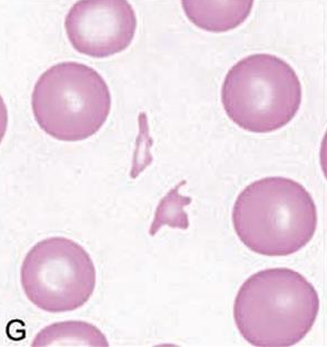

Table of Contents
(๋๋ฅด๋ฉด ์ด๋ํ๋ ๊ฑด,, ์ฌ๊ธฐ์ ๊ตฌํ์ด ์๋จ ,, ใ ใ ์์๋ง ์ญ ๋ณด์ธ์ฉ ใ )
- โ . Erythron
- โ ก. Erythrocyte kinetics in health
- [[#โ ก. Erythrocyte kinetics in health#(1) ๊ณจ์ (Erythrocyte precursors)|(1) ๊ณจ์ (Erythrocyte precursors)]]
- [[#โ ก. Erythrocyte kinetics in health#(2) ์ํ ํ์ค (Blood erythrocytes)|(2) ์ํ ํ์ค (Blood erythrocytes)]]
- [[#โ ก. Erythrocyte kinetics in health#(3) ๋น์ฅ (Splenic erythrocytes)|(3) ๋น์ฅ (Splenic erythrocytes)]]
- โ ๋๋ฌผ๋ณ ์ ์ RBC ๋น๊ต
- โ ข. Hgb
- [[#โ ข. Hgb#Hgb synthesis|Hgb synthesis]]
- [[#โ ข. Hgb#Hgb degradation|Hgb degradation]]
- โ ฃ. Fe
- [[#โ ฃ. Fe#Absorption|Absorption]]
- โ ค. Mature erythrocyte metabolism
- โ ฅ. Reticulocytes
- [[#โ ฅ. Reticulocytes#Feline Reticulocytes์ ์ข ๋ฅ|Feline Reticulocytes์ ์ข ๋ฅ]]
- โ ฆ. Blood groups or types
- โ . Erythrogram
- โ ก. Methods
- [[#โ ก. Methods#(1) Microhematocrit|(1) Microhematocrit]]
- [[#โ ก. Methods#(2) Impedance cell counters|(2) Impedance cell counters]]
- [[#โ ก. Methods#(3) Laser flow cell cytometers (+Cytogram ๋ถ์๐)|(3) Laser flow cell cytometers (+Cytogram ๋ถ์๐)]]
- โ . Assessment
- โ ก. General Features
- [[#โ ก. General Features#Mature RBC = Discocytes (์ ์ ์ ํ๊ตฌ)|Mature RBC = Discocytes (์ ์ ์ ํ๊ตฌ)]]
- [[#โ ก. General Features#Rouleaux formation or Agglutination|Rouleaux formation or Agglutination]]
- [[#โ ก. General Features#Rubricytosis|Rubricytosis]]
- โ ข. RBC Color
- โ ฃ. RBC Organisms
- โ ค. RBC Inclusions (other than organisms)
- โ ฅ. Abnormal Erythrocyte Volume
- โ ฆ. Abnormal Erythrocyte Shape
- โ . General information
- โ ก. Classifications of anemias
- [[#โ ก. Classifications of anemias#โบ๏ธ Bone marrow์ ๋ฐ์์ฑ|โบ๏ธ Bone marrow์ ๋ฐ์์ฑ]]
- [[#โ ก. Classifications of anemias#โบ๏ธ RBC indices์ ๋ฐ๋ฅธ ์ธํฌ์ mophologic classification|โบ๏ธ RBC indices์ ๋ฐ๋ฅธ ์ธํฌ์ mophologic classification]]
- [[#โ ก. Classifications of anemias#โบ๏ธ Pathophysiologic classification|โบ๏ธ Pathophysiologic classification]]
- โ . General concepts
- โ ก. Disorders that cause nonregenerative anemias
- โ . Causes of blood loss
- โ ก. Classification based on duration and location
- โ . Concepts and classifications
- โ ก. Hemolytic disorders and diseases
- โ . Terms and concepts
- โ ก. Erythrocytotic disordes and conditions
๋จ์ ๋ชฉํ
- ๋นํ์ ๊ณจ์์ ๋ฐ์์ฑ ์ ๋ฌด์ ๋ฐ๋ผ ๋น์ฌ์์ฑ ๋นํ๊ณผ ์ฌ์์ฑ ๋นํ(by blood loss or hemolysis)๋ก ๊ตฌ๋ถํ ์ ์๋ค.
- Erythrogram๋ง ๋ณด๊ณ ๋ ์ด๋ค ๋นํ์ธ์ง ํ๋จํ ์ ์์ด์ผ ํ๋ค !!
- ๋นํ ์ง๋จ์ด ์ ์ผ ํต์ฌ ํฌ์ธํธ
(Erythrocytosis, polycythemia๋ ์์ฃผ ๋ณด์ด๋ ์ผ์ด์ค๊ฐ ์๋. ๋ค๋ฅธ RBC ๊ด๋ จ ์งํ๋ค๋ ๋๋ถ๋ถ ์ ์ ์ ์ผ๋ก ๋ฐ์ํ๋ ๊ฒ์ด์ง, ์ค์ ๋ก ๋ณด๊ฒ ๋๋ ์ผ์ด์ค๋ ์ ํ์ .)- ๊ทธ ์ธ, ํ์ค Fe ๋๋๋ฅผ ํ๊ฐํ๋ ๋ฐฉ๋ฒ๊ณผ blood typing์ ์ข ๋ฅ๋ ๋ฐฐ์ธ ๊ฒ.
์ถ๊ฐ ์ฌ์ง from ๋จ๋ด
Physiologic Processes
โ . Erythron
- RBC ๊ณํต์ ๋ชจ๋ ์ธํฌ. (๊ฐ, ๋น์ฅ, ๊ณจ์, ํ๊ด์ ๋ชจ๋ erythrocyte์ precursors๊ฐ ํฌํจ๋๋ค.)
- ๋ค์ํ cytokines๊ฐ EPO์ ๊ฐ์ด ์๊ทน์ ์ ๋ฐํ๋ฉด โ BFU-E๋ก๋ถํฐ RBC precursor ๊ฐ ์์ฑ๋๋ค.
* BFU-E : blast-forming unit-eythroid - Erythropoiesis๋ hematopoiesis ์ค ํ๋๋ก ํฌํจ๋๋ค.
EPO(erythropoietin)
Erythropoiesis๋ฅผ ์๊ทนํ๋ ํธ๋ฅด๋ชฌ.
ํ์๊ธฐ์๋ ๊ฐ์์, ์ฑ์ฒด์์๋ ์ ์ฅ์ renal peritubular interstitial cell์์ ์ฃผ๋ก ์์ฐ๋๋ค.
- Renal hypoxia์ ๋ํ ๋ฐ์์ผ๋ก EPO๊ฐ ์์ฐ๋๋ฉด โ EPO๊ฐ erythropoiesis๋ฅผ ์ ๋.
- Renal hypoxia : ๋นํ์ด๋, ํ์งํ, ์ฐ์ ๊ตํ ๋ถ์กฑ, ์ ์ฅ ๊ด๋ฅ ์ด์ ๋ฑ์ผ๋ก ๋ฐ์
- ๋ฐ๋ผ์ ๊ณจ์๊ฐ ์๋๋ผ EPO๋ฅผ ์์ฑํ๋ ์ ์ฅ์ ๋ฌธ์ ๊ฐ ์๊ฒผ์ ๋๋ ๋นํ์ด ๋ํ๋ ์ ์๋ค.
- CKD๋ ๊ฐ๋ณด๋ค ๊ณ ์์ด์์ ๋ง์ด ๋ํ๋๋๋ฐ(๊ฐ๋ 1/5 ์์ค, ๊ณ ์์ด๋ ์ ๋ฐ/5 ์์ค),
CKD๊ฐ ์์ผ๋ฉด renal peritubular interstitial cell์์ EPO๋ฅผ ์ ์์ฑํ์ง ๋ชปํด ๋นํ์ด ๋ฐ์ํ๋ค.
- RBC ๊ณํต์ ์ธํฌ๋ ๊ณจ์์ ์๋ ์ธํฌ, ํ์ก ์ค ์ํํ๋ ์ธํฌ, ๋น์ฅ์ ์ ์ฅ๋ ์ธํฌ๋ก ๊ตฌ๋ถํ ์ ์๋ค.
โ ก. Erythrocyte kinetics in health

๊ณจ์ / ์ํ ํ์ค / ๋น์ฅ ์ ์ฅ์ 3๊ฐ์ง ํํ.
(1) ๊ณจ์ (Erythrocyte precursors)
- CFU-E โ rubriblast(Rb) โ prorubricyte(Pr) โ rubricyte(Rc)๋ก ๋ถ์ดํ๊ณ ,
metarubricyte(Mr) โ reticulocyte(Rt) โ eyrthrocyte(E)๋ก ์ฑ์ํ๋ ๊ณผ์ ์ด ๊ด์ฐฐ๋๋ค. - ์ฑ์ํ ์๋ก ํต์ ํํ๊ฐ ์๊ณก๋๋ฉด์ ์ ์ segmented๋๋ WBC์ ๋ฌ๋ฆฌ,
RBC๋ ์ฑ์ํ๋ฉด์ ์ธํฌ ํฌ๊ธฐ๋ ์์์ง๊ณ , ํต์ roundํ ํํ๋ฅผ ์ ์งํ๋ค.
Reticulocyte
- Metarubricyte โ reticulocyte๊ฐ ๋๋ฉด์ ํํต์ด ์ผ์ด๋๊ณ mature RBC์ ์ ์ฌํ anucleate cell์ด ๋๋ค.
- ํํต๋ ํต์ macrophage์ ์ํด ํ์๋๋ค.
- ๊ทธ๋ฌ๋ ์ฌ์ ํ ์ผ์๋ ์ ์๋ RNA ์์ฌ๋ฌผ๋ค์ด ์ธํฌ์ง์ ๋จ์์๊ธฐ ๋๋ฌธ์ RBC์ฒ๋ผ ๋ช ํํ๊ฒ ํธ์ฐ์ฑ์ ๋ ์ง๋ ์๊ณ , metarubricyte์ฒ๋ผ ์ฌ์ ํ ํธ์ผ์ฑ๊ณผ ํธ์ฐ์ฑ์ด ์์ฌ ์๋ ์ผ์์ฑ์ ๋ํ๋ธ๋ค.
- Reticulated form(๊ทธ๋ฌผ ๋ชจ์)์ผ๋ก ์ผ์์ฑ์ด ์กด์ฌํ๊ธฐ ๋๋ฌธ์ โreticulocyteโ ๋๋ โpolychromatophilic erythrocyteโ๋ผ๊ณ ๋ถ๋ฅธ๋ค.
- Hemoglobin ํฉ์ฑ์ rubriblast โ reticulocyte๊น์ง, ์ฆ mature RBC๊ฐ ๋๊ธฐ ์ ๊น์ง ์ง์์ ์ผ๋ก ๋ํ๋๋ค.
- ๋ํ ํค๋ชจ๊ธ๋ก๋น ํฉ์ฑ์ด ์์ฑ๋ ๋๊น์ง๋ ์ธํฌ ๋ถ์ด์ด ์ผ์ด๋๋ค.
์ธํฌ ํฌ๊ธฐ๋น ํค๋ชจ๊ธ๋ก๋น ์ ์ ๋๋๋ฅผ ๋ง์ถ ๋๊น์ง ๋ถ์ด์ด ์ผ์ด๋๋ ๊ฒ์ด RBC ์ฑ์ ๋ถํ์ ํน์ง!- ๋ฐ๋ผ์ โHemoglobin ํฉ์ฑ์ด ์ผ์ด๋๊ณ ์๋คโ = โimmature RBC์ด๋คโ
(2) ์ํ ํ์ค (Blood erythrocytes)
- ํต์ด ์๋ mature RBC ํํ๋ก ํ์ค์ผ๋ก ๋ฐฉ์ถ๋์ด ์ฐ๋ฆฌ๊ฐ ์๋ ์ฐ์ ์ด๋ฐ์ ์ญํ ์ ์ํํ๋ค.
- ๊ฑด๊ฐํ ํฌ์ ๋ฅ์์ ์๊ฐ/์ฒด์ค(kg)๋น 250 million RBC์ cell death๊ฐ ์ผ์ด๋๋ค.
- Life span์ ๋คํ old RBCs๋ splenic, hepatic, bone marrow ๋ฑ์ tissue macrophage์ ์ํด ์ ๊ฑฐ๋๋ค.
- ์ฃฝ์ ๋๊ฐ ๋ ๋์ด๋ RBC๋ค์ spheroid(3์ฐจ์ ๊ตฌ) ํํ๋ก ๋ชจ์์ด ๋ฐ๋๊ณ , sinus ํต๊ณผ๋ ๊ฐ์ํ๋ค.
(3) ๋น์ฅ (Splenic erythrocytes)
- ๋น์ฅ์์๋ mature RBC ์ ์ฅ pool์ ์ญํ ์ ์ํํ๋ค.
- ๊ณ ์์ด๋ฅผ ์ ์ธํ๊ณ ๊ฐ, ๋ง, ์์์๋ ๋น์ฅ์ sinusoids์ red pulp์ ์๋น๋์ RBC๋ฅผ ์ ์ฅํ๋ค.
- ๋ง์ ์ ์ฅ๋ฅ์ด ๊ฐ์ฅ ๋ฐ์ด๋๋ค(50~60%์ RBC).
- Life span์ด ๋คํ๊ฑฐ๋, ์์๋ RBC๋ค์ด splenic macrophage์ ์ํด ์ ๊ฑฐ๋๋ ๊ธฐ๋ฅ๋ ์๋ค.
๊ณ ์์ด spleen์ ํน์ง (Closed circulation)
- ๊ฐ, ๋ง, ์์์๋ open circulation์ด ์ด๋ฃจ์ด์ง๊ณ , ์ ์ฅ ๋ฅ๋ ฅ์ด ๋๋ค.
- open circulation : ํ๋ฅ๊ฐ splenic artery์์ โ sinusoid๋ฅผ ํตํด ๋น์ฅ ์ค์ง๊ณผ ์ ๋งฅ์ ํต๊ณผํ๊ณ โ ๋ฐ๊นฅ์ผ๋ก ๋ฐฉ์ถ.
- ๊ณ ์์ด์ ๋น์ฅ์ closed circulation์ ํ๊ธฐ ๋๋ฌธ์, RBC ์ ์ฅ๋ณด๋ค๋ ๋ฉด์ญ ๊ธฐ๋ฅ์ ์น์ค๋์ด ์๋ค.
- Closed circulation : ๋น์ฅ ์ค์ง์ ๋ ธ์ถ๋์ง ์๊ณ ๋น์ฅ ๋๋งฅ โ ์ ๋งฅ โ ๋ค๋ฅธ ์ฅ๊ธฐ.
- RBC๋ค์ด ๋น์ฅ ์ค์ง์ macrophage์ ๋ ธ์ถ๋ ์ผ์ด ๊ฑฐ์ ์์ด ์์๋ RBC๋ฅผ ์ ๊ฑฐํ๋ ๊ธฐ๋ฅ์ ๋จ์ด์ง๋ค.
- ๊ทธ๋์ ๊ณ ์์ด์ ํ์ก์์๋ old cell๋ค์ด ๋ ๋น๋ฒํ๊ฒ ๊ด์ฐฐ๋๋ค.
Figure ๋ณต์ต
- Hemoglobin ํฉ์ฑ์ reticulocyte(polychromatophil) ๋จ๊ณ๊น์ง ์ผ์ด๋๋ค๋ ์ ๊ธฐ์ต.
- ๊ฐ์ ๊ณ ์์ด์์, ๋นจ๊ฐ ๋ค๋ชจ์ ๋ ์ธํฌ(Reticulocytes & Mature RBCs)๋ ์ํ ํ์ค์์๋ ๊ด์ฐฐ๋ ์ ์๋ค.
- RBC precursor์์ Hgb ํฉ์ฑ์ด ๋ถ์ถฉ๋ถํ๋ฉด ์ถ๊ฐ์ ์ธ mitoses๊ฐ ์ผ์ด๋, ์ธํฌ๊ฐ ๋ ์์์ง๋๋ผ๋ Hgb ํฉ์ฑ์ ๊ณ์ํ๋ค. โ [Hgb] ๋ถ์กฑํ๋ฉด ์ ์ RBC๋ณด๋ค ๋ ์์์ง ๋๊น์ง ๋ถ์ด์ด ์ผ์ด๋๋ค๋ ๊ฒ์ด RBC์ ํน์ง!
- Spleen์์ RBC๋ฅผ ์ ์ฅํ๊ณ ์์ผ๋ฉฐ, ๊ต๊ฐ์ ๊ฒฝ์ ์์ฉ์ผ๋ก ์์ถํ๋ฉด ์ ์ฅ๋์ด ์๋ RBC๊ฐ ๊ฐ์๊ธฐ ๋ฐฉ์ถ๋ ์ ์์.
- ๋ง์ ์ ์ฅ๋ฅ์ด 50-60%๋ก ๊ฐ์ฅ ํฌ๋ค. (๊ฒฝ์ฃผ๋ง ๋ฌ๋ฆฌ๊ณ ๋์ ์ฑํํ๋ฉด RBC ์์น๊ฐ ์ด๋ง์ด๋ง..)
- ๊ทธ ์ธ์ ๋๋ฌผ์์๋, ๊ต๊ฐ์ ๊ฒฝ์ด ์๊ทน๋๋ฉด ์ผ์์ ์ผ๋ก erythrocytosis๊ฐ ๋ํ๋ ์ ์๋ค.
โ ๋๋ฌผ๋ณ ์ ์ RBC ๋น๊ต

| ๋๋ฌผ๋ณ Blood erythrocyte ๋น๊ต | |
|---|---|
| Reticulocyte concentration | - ๊ฐ์ ๊ณ ์์ด์์๋ reticulocytes๊ฐ ์ ์์ ์ผ๋ก ๊ด์ฐฐ๋๋ค. (1-2์ผ ํ mature RBCs) - ๋ง, ์์์๋ ์ ์์ ์ผ๋ก ๊ด์ฐฐ๋์ง ์๋๋ค. |
| RBC life span | - ํฌ์ ๋ฅ์ ํ๊ท ์ ํ๊ตฌ ์๋ช
์ 120์ผ ์ ๋. - ๊ณ ์์ด๋ 70์ผ๋ก ๋ง, ์์ ๋นํด ์ ๋ฐ ์์ค์ด๋ค. |
| RBC diameter & volume | - ์ง๊ฒฝ ์ฐจ์ด๋ ํฌ์ง ์๋ค. - ์ ํ๊ตฌ ๋ถํผ๋ ๊ฐ์์ ๊ฐ์ฅ ํฌ๊ณ , ๋ง๊ณผ ๊ณ ์์ด์์ ์๋ค. |
| RBC central pallor | - ๊ฐ์์๋ ๋๋ ทํ๊ฒ ๊ด์ฐฐ๋๋, ๋๋จธ์ง ์ข ์์๋ ๋ถ๋ถ๋ช ํ๋ค. |
โ ข. Hgb
๊ตฌ์กฐ, ๊ธฐ๋ฅ์ ์ฝ์ด๋ณด๊ธฐ (๋ค ์์ฃ ?)
Hgb synthesis
- ํค๋ชจ๊ธ๋ก๋น ํฉ์ฑ์ RBC precursors๋ก๋ถํฐ ์ผ์ด๋๋ค. (rubriblast~reticulocyte๊น์ง)
Fig 3.2. Erythrocyte์์์ hemoglobin synthesis
- (1) Porphyrin reaction - (2) ์ฒ ์ incorporation of Fe2+ - (3) Globulin์ binding
- ๋ฉ ์ค๋ ์ฆ(lead toxicity)
โ porphyrin reaction์ ๊ด์ฌํ๋ ํจ์์ ๊ธฐ๋ฅ์ด ์ต์ ๋จ
โ porphyrin์ด ๊ณ์ ์ถ์ ๋จ
โ porphyria ๋ฐ์ (ํฌ๋ฅดํผ๋ฆฐ์ฆ: ์ ํ๊ตฌ, ํ์ฅ, ์๋ณ์ porphyrin ๋๋๊ฐ ์์นํ ์ํ)
- ferriheme & globin binding ๊ณผ์ ๋ ์ต์ ๋์ด methemoglobin์ด ์๊น.
- lead toxicity๋ก ์ธํด porphyria๊ฐ ๋ฐ์ํ ์ ์๋ค๋ ๊ฒ์ ์๊ณ ์์.
Hgb degradation
- Macrophage์์ ์ผ์ด๋๋ค: ๋น์ฅ, ๊ฐ, ๊ณจ์์ macrophage (RBC ์ ๊ฑฐ์ ๋์ผ)
- Hgb ๋ถํด โ Heme + globin โ Heme์ด [biliverdin + Fe2+ + CO]๋ก ๋ถํด โ bilirubin ํ์ฑ
- ์ด ์ค ์ฒ ๊ณผ ์๋ฏธ๋ ธ์ฐ์ ์ฌ์ฌ์ฉ๋์ด hemoglobin ํฉ์ฑ ๋ฑ์ ์ด์ฉ๋๋ค.
Fig 3.3. Bilirubin metabolism
- Hemoglobin์ ๋ถํด ์ฐ๋ฌผ์ธ bilirubin์ ์ฅ์ ํตํด ๋ถ๋ณ์ผ๋ก / ์ ์ฅ์ ํตํด urine์ผ๋ก ๋ฐฐ์ถ๋๋ค.
- Unconjugated bilirubin์ ์ฃผ๋ก albumin๊ณผ binding๋ ํํ๋ก ์ํ ํ์ค์ ์กด์ฌํ๋ค.
- ๊ฐ์ธํฌ์์ uptake๋๋ฉด conjugation form์ผ๋ก ์ ํ โ ๋ฐฐ์ถ๋๋ค.
- Hemolytic anemia๋ก ์ฉํ์ด ์ฆ๊ฐํ๋ฉด, ๊ฐ์ธํฌ์ conjugation ๋ฅ๋ ฅ์ ์ด๊ณผํ์ฌ ํฉ๋ฌ์ด ๋ฐ์ํ ์ ์๋ค.
- ํฉ๋ฌ์ด ๊ฐ์ธํฌ์ ์ํด์๋ง ์ผ์ด๋๋ ๊ฒ ์๋๋ผ, ๊ฐ ์งํ๊ณผ ์๊ด์์ด๋ prehepatic์ด๋ posthepatic jaundice๊ฐ ๋ฐ์ํ ์ ์๋ค๋ ์ ์ ๊ธฐ์ตํ์.
ํฉ๋ฌ์ ์ข ๋ฅ 3๊ฐ์ง
- Bilirubin์ ์ ์์ ์ผ๋ก ๊ฐ์ธํฌ์์ conjugation form์ผ๋ก ๋ฐ๋์ด ๋ชธ ๋ฐ์ผ๋ก ๋ฐฐ์ถ๋๋ค.
- Hepatic jaundice : ๊ฐ์ธํฌ์ ๋ฌธ์ ๊ฐ ์๊ฒจ unconjugated bilirubin์ด ์ฆ๊ฐ
- Prehepatic jaundice : hemolysis๊ฐ ๋ง์ด ์ผ์ด๋ ๊ฐ์ธํฌ๊ฐ conjugation ์ํฌ ์ ์๋ ๋ฅ๋ ฅ์ ์ด๊ณผํจ - unconjugated bilirubin ์ฆ๊ฐ
<< Hemolytic anemia์ ์ํด ๋ฐ์ ๊ฐ๋ฅ- Posthepatic jaundice : ์ ์ฅ ์งํ ๋ฑ์ผ๋ก ์ธํด ์ ์์ ์ผ๋ก ๋ฐฐ์ถ๋์ง ๋ชปํจ
- ๊ฐ๊ฐ์ ๊ฒฝ์ฐ์์ ๊ด์ฐฐ๋๋ bilirubin์ด conjugated form์ธ์ง unconjugated form์ธ์ง ๊ตฌ๋ถํ ์ ์์ด์ผ ํจ.
โ ฃ. Fe
- ์์ฒด ๋ด ์ฒ ์ ์ฃผ๋ก 3๊ตฐ๋ฐ์ ๋ถํฌํ๋ค.
- (1) ์ฒด๋ด ์ฒ ์ 50% ์ด์์ RBC hemoglobin ๋ด์ ์กด์ฌ.
- (2) 25-40%๋ ์ ์ฅํ์ผ๋ก ์กด์ฌ : plasma, tissue, ferritin, tissue macrophage ๋ด์ hemosiderin ํํ
- (3) ๊ทธ ์ธ ์์ฃผ ์๋์ myglobin, cytochrome, enzyme ๋ฑ์ ์กด์ฌ.
- ์์ฒด ๋ด์์ ์ฒ ๋์ฌ ์ด์์ด ๋ฐ์ํ๋ฉด ๊ฑฐ์ RBC hemogloblin์ ๋ฌธ์ ๋ผ๊ณ ๋ณด๋ฉด ๋๋ค.
ํค๋ชจ๊ธ๋ก๋น ๋๋, ์์ฒด ๋ด ์ฒ ์ ์ฅ ์ํ ๋ฑ์ ํ๊ฐํด์ผ ํ๋ฏ๋ก ์ฒ ์ด ์ด๋์ ๋ง์ด ์กด์ฌํ๋์ง ์์์ผ ํจ.
Absorption
- ์ฒ ์ ์ฃผ๋ก ์์ด(diet)๋ฅผ ํตํด ํก์๋๋ค.
- ๊ฐ์ธํฌ์์ ์์ฑ๋๋ hepcidin ํธ๋ฅด๋ชฌ์ โ ์ฅ์์์ ์ฒ ํก์๋ฅผ ์กฐ์ ํ๋ค.
- ๊ฐ์ธํฌ์์ hypoxia ๊ฐ์งํ๋ฉด hepcidin ์์ฑ์ด ๋ฐ๋ก ๊ฐ์ โ RBC๊ฐ ์ฒ ์ ๋ง์ด ์ด์ฉ โ hemoglobin์ ํฉ์ฑ์ด ์ฆ๊ฐํ๋ค.
- ์ผ์ฆ ์ inflammatory cytokine ์ค ํนํ IL-6์ ์ํด hepcidin ํฉ์ฑ์ด ์ฆ๊ฐํ๋ค.
Fig 3.4. Fe kinetics in healthy animals
- ์ํ ํ์ค์ RBC ์์ Fe2+๊ฐ ์กด์ฌํ๊ณ ์๋ค.
- ์ฅ์ ํตํด ํก์๋ ์ฒ ์ ์ํ ํ์ค์์ ์ด์จ(Fe2+)์ด ์๋๋ผ transferrin ํํ๋ก ์กด์ฌํ๋ค.
- Transferrin = apotransferrin(์ฒ ์ ์ด๋ฐ ๋จ๋ฐฑ์ง) + ์ฒ ์ด ๊ฒฐํฉ๋ ํํ
- ์ด ํํ๋ก spleen, hepatic์ผ๋ก ์ด๋ํ๊ธฐ๋ ํ๋ค.
- ํน์ ํ์ค์ด๋ ์กฐ์ง์ ferritin ํํ๋ก๋ ์ ์ฅ๋์ด ์๋ค.
โ ค. Mature erythrocyte metabolism
- ๋๋ถ๋ถ์ ํฌ์ ๋ฅ์ RBC๋ glucose๋ฅผ ์๋์ง์์ผ๋ก ์ด์ฉํ๋ค.
- ๋จ, ๋ผ์ง๋ glucose transporter๊ฐ ๊ฑฐ์ ์๊ธฐ ๋๋ฌธ์ glucose ๋์ inosine์ ์ด์ฉํ๋ค.
โ ฅ. Reticulocytes
(์ผ) NMB (์ค) Diff-quik
- ํต์ ํ์๋์์ผ๋ ์ธํฌ์ง์ staining ๊ฐ๋ฅํ RBC ์์ฌ๋ฌผ๋ค์ด ์์ง ๋จ์์๋ค,
- NMB staining์ ํ๋ฉด โ RNA ์์ฌ๋ฌผ๋ค์ด reticulated basophilic structure ํํ๋ก ๊ด์ฐฐ๋๋ค.
- NMB staining์ผ๋ก reticulocyte๋ฅผ ๋ช
ํํ๊ฒ ๊ตฌ๋ถํ ์ ์๋ค.
๊ทธ๋์ ๋นํ ํ์์์ [NMB staining โ reticulocyte counting]์ ์์ฃผ ์ฌ์ฉ๋๋ ๋ฐฉ๋ฒ์ด๋ค. - NMB staining์ ์ธํฌ ๋ฐฐ์ ์ ์ด์์๋ ์ธํฌ์ cell counting์๋ ์ด์ฉ๋๋ค.
- NMB staining์ผ๋ก reticulocyte๋ฅผ ๋ช
ํํ๊ฒ ๊ตฌ๋ถํ ์ ์๋ค.
- ์ผ๋ฐ์ ์ผ๋ก ํ๋ Diff-quik๋ Wright-staining์์๋ polychoromatophilic erythrocyte ํํ๋ก ๋ณด์ธ๋ค.
- ์ธํฌ ํฌ๊ธฐ๊ฐ ์กฐ๊ธ ๋ ํฌ๊ณ , central pallor๊ฐ ๋ถ๋ถ๋ช ํ๋ฉฐ, ํธ์ฐ์ฑ์ด ์กฐ๊ธ ์์ฌ ์๋ ์ผ์์ฑ.
- Circulating reticulocytes๊ฐ ๊ฐ์ ๊ณ ์์ด์์ ๊ด์ฐฐ๋ ์ ์๋ค / ๋ง๊ณผ ์์์๋ ๊ด์ฐฐ๋๋ฉด ์ ๋จ!
- 1-2์ผ ํ mature RBC๊ฐ ๋๋ค.
Feline Reticulocytes์ ์ข ๋ฅ

- ๊ฐ์๋ ๋ฌ๋ฆฌ, ๊ณ ์์ด์์ NMB staining์ ํ๋ฉด 2๊ฐ์ง ํํ๋ก ๊ด์ฐฐ๋๋ค.
- (1) Punctate type : reticulum ์ ์ (2-6๊ฐ ์ ๋)
- (2) Aggregate type : reticulum์ด ํจ์ฌ ๋ง์, ๊ณจ์์์ ๋ฐฉ์ถ๋ ์ง ์ผ๋ง ์ ๋จ
- ๋ค๋ฅธ ํ
์คํธ์์๋ Type โ
, โ
ก, โ
ข๋ก ๊ตฌ๋ถํ๊ธฐ๋ ํ๋ค.
- Type โ (=punctate type) : reticulum ๊ฑฐ์ ์์. ๋ฐฉ์ถ๋ ์ง ์ค๋ ๋์ด life span์ 3์ผ ์ ๋.
- Type โ ก : life span์ 12์๊ฐ ์ ๋ (12์๊ฐ ์ง๋๋ฉด type โ ํํ๋ก ๋ฐ๋.)
- Type โ
ข : reticulum์ด ๊ฐ์ฅ ๋ง์. ๊ณจ์์์ ๋ฐฉ์ถ๋ ์ง ๊ฐ์ฅ ์ผ๋ง ์ ๋ ์ธํฌ๋ค.
- life span์ 12์๊ฐ ์ ๋, ๋นํ ์์ ํ 4์ผ ์ ๋ ์ง๋์ผ concentration์ด ๋์์ง.
- ์ด๋ฌํ ๋ถ๋ฅ๋ฅผ ํตํด blood loss ํน์ hemolysis๊ฐ ์ผ๋ง๋ ์ง์๋์๋์ง ํ๊ฐํ ์ ์๋ค.

- ์ผ์ชฝ : NMB staining๋ก ํ์คํ๊ฒ ๊ตฌ๋ถํ ์ ์๋ค. (A=aggregate form, P=punctate form)
- ์ค๋ฅธ์ชฝ : Diff-quik staining์์๋ ํต ์์ฌ๋ฌผ์ด ๋จ์ ์๋ polychromatophilic RBC์ ํํ๋ก ๊ด์ฐฐ๋๋ค.
RC, CRP
* RC : reticulocyte concentration, CRP : corrected reticulocyte percentage
- Correction์ด ํ์ํ ๊ฒ์๋ WBC, reticulocyte๊ฐ ์๋ค.
- CRP(corrected)๋ ๊ฒฐ๊ตญ Absolute reticulocyte percentage๋ฅผ ๋ํ๋ธ๋ค.
- ๊ฑด๊ฐํ ๋๋ฌผ์์๋ ๊ฑฐ์ RC=CRP ์ด๋, ๋นํ์ด ์๋ ๋๋ฌผ์์๋ correction์ด ํ์ํ๋ค.
- CRP ๊ณต์ : ์ ์ PCV, ํ์์ PCV, RP ๊ฐ์ผ๋ก ๊ตฌํ ์ ์๋ค. ๊ธฐ๊ณ๊ฐ ๊ณ์ฐํด์ฃผ์ง๋ง, ์ด๋ค ์๋ฏธ์ธ์ง๋ ์๊ณ ์์!
-
Reticulocytosis๊ฐ ์๋ค = polychromasia๊ฐ ์ฆ๊ฐํ๋ค, RC ์ฆ๊ฐ, CRP ์ฆ๊ฐ
-
Reticulocytosis๋ erythropoiesis๊ฐ ์ฆ๊ฐํ์์ ์๋ฏธํ๋ค.
-
polychromasia์ ์ ๋(degree)๋ reticulocytosis์ ์ ๋์ ๋ฐ๋ผ ์ฆ๊ฐํ๋ค.
| ๋๋ฌผ๋ณ | Reticulocytosis |
|---|---|
| ๋ง & ์ | ์ ์์ ์ผ๋ก reticulocyte๊ฐ ๊ด์ฐฐ๋์ง ์๋๋ค. |
| - ๋ง : Circulating polychromatophilic erythrocytes๋ฅผ ๊ด์ฐฐํ๊ธฐ๊ฐ ๊ฑฐ์ ์ด๋ ต๋ค. | |
| - ์ : ๋นํ ๋ฐ์ 3-4์ผ ๋ค reticulotytosis๊ฐ ๋ํ๋, 7-14์ผ์ฏค ๊ฐ์ฅ ๋์ ๊ฐ์ ๋ํ๋ธ๋ค. | |
| ๊ฐ | Bovine pattern : ์์ ๋ง์ฐฌ๊ฐ์ง๋ก, 3-4์ผ ์ดํ reticulocytosis๊ฐ ๋ํ๋์ 10์ผ์ฐจ์ ๊ฐ์ฅ ๋์ ๊ฐ์ ๋ํ๋ธ๋ค. |
![]() (blood loss 3์ผ ์ดํ reticulocytosis ์ผ์ด๋๋ ๊ฒ ํ์ธ) | |
| ๊ณ ์์ด | aggregate form, punctate form์ ๋ฐ๋ผ ์ฐจ์ด๊ฐ ์๋ค. |
| polycythemia(RBC์ฆ๊ฐ์ฆ)์ด ์๋ ๊ณ ์์ด์์ Hct๋ฅผ 50% ์์ค์ผ๋ก ๋ง์ถฐ์ฃผ๊ธฐ ์ํด ์ ๋งฅ์ ๊ฐ์ (phlebotomies)์ ์ค์ํ์ ๋, - Aggregate reticulocytosis : ์ฝ day 2์ ๊ด์ฐฐ๋๊ณ 4์ผ์งธ peak, 9์ผ์งธ ๋ค์ baseline์ผ๋ก ๋์๊ฐ๋ค. - Punctate reticulocytosis : day 1์ ๋ํ๋ 7-14์ผ์งธ peak๋ฅผ ๊ธฐ๋กํ๊ณ ๋ค์ baseline์ผ๋ก ๋์๊ฐ์ง ์์๋ค. | |
![]() (ํ์ค์ ๋ ๋ง์ด ์กด์ฌํ๋ ๊ฒ์ punctate form, aggregate form ๋ํ anemia๋ก๋ถํฐ ์๊ฐ์ฐจ๋ฅผ ๋๊ณ ์ฆ๊ฐํ๋ ๊ฒ ํ์ธ) |
๊ตฌ์ฒด์ ์ธ ๋ ์ง๋ ๋ชฐ๋ผ๋, ์์ ๊ฐ์ ๊ณ ์์ด์์ blood loss ์ดํ ๋ฉฐ์น ์ ์๊ฐ์ฐจ๋ฅผ ๋๊ณ reticulocytosis๊ฐ ์๊ธด๋ค๋ ์ฌ์ค์ ๊ธฐ์ตํ์. >> ๋นํ์ ๋ฐ์ ์๊ธฐ๋ฅผ ์ญ์ผ๋ก ์ถ์ ํ ์ ์๋ ๊ทผ๊ฑฐ๊ฐ ๋๋ค.
PCV์ RP ๊ฐ
์ฌ์์ฑ ๋ฐ์์ด ์ถฉ๋ถํ ๊ฐ์ ๊ณ ์์ด์์ HCT์ ๋ฐ๋ฅธ RP
- ์ ์ (PCV=45%) : RP < 1.0% ๊ฐ ์ผ๋ฐ์ .
- ๋นํ (PCV 35~10%)
- PCV๊ฐ ๊ฐ์ํ๋ฉด์ ๊ณจ์๊ฐ ์ ์์ ์ธ ์ฌ์์ฐ์ ํ๋ค๋ฉด RP๊ฐ 4๋ฐฐ ๊ฐ๋ ์ฆ๊ฐํจ.
- ๊ณ ์์ด์์๋ ๊ฐ reticulocyte form์์ RP๊ฐ ์ฆ๊ฐํจ.
- Aggregate RP๋ PCV 20~10%์ผ ๋ 4๋ฐฐ ์ด์ ์ฆ๊ฐ.
| Hematocrit ๊ฒฐ๊ณผ ๋ถ์ |
|---|
![]() * ํ์ก ์์ฌ๋ถ๋ฆฌ ์ 3,000rpm, 10min. |
| Normal (45%) |
| Anemia (30%) : hematocrit(PCV)์ ๊ฐ์ ํ์ธ |
| Polycythemia (70%) (=erythrocytosis) : ์ ์์ ๋นํด RBC volume์ด ํฌ๋ค. ์ ๋ง์ด paleํ ๊ฒ์ด ์๋๋ผ, ๋ฐ๋๋ก ์์ฃผ ๋ถ๊ฒ ์ถฉํ๋ ๊ฒ์ฒ๋ผ ๊ด์ฐฐ๋๋ค. |
| Dehydration (70%) : hematocrit ์ฆ๊ฐ, plasma ์ ๊ฐ์. ํ์ ํ์์์ ๊ด์ฐฐ๋๋ค. (RBC๊ฐ ์ค์ ๋ก ์ฆ๊ฐํ ๊ฒ ์๋๋ผ, ์ ์ฒด volume์ด ์ค์ด ์๋์ ์ผ๋ก RBC๊ฐ ์ฆ๊ฐํ ๊ฒ์ฒ๋ผ ๋ณด์.) : ๊ตฌํ , ์ค์ฌ, ํ์(๋ณ์ ์จ์ด ๋งคํธ, ๋๋ฌผ ํ๋) ์ ๋ํ๋ ์ ์๋ค. |
| โ Hematocrit๋ง ๋ด๋ ๋นํ ์ฌ๋ถ์ ์ ๋๋ฅผ ํ๊ฐํ ์ ์๋ค. |
โ ฆ. Blood groups or types
- Blood group์ ์ ์ ์ ์ธ์์ ์ํด ๊ฒฐ์ ๋๋ค.
- RBC๊ฐ ๊ฐ์ง๋ antigen๊ณผ plasma๊ฐ ๊ฐ์ง๋ antibody์ ๋ฐ๋ผ ์ํ ๊ฐ๋ฅ ์ฌ๋ถ๊ฐ ๋ฌ๋ผ์ง๋ค. ๋ฐ๋์ ์ํ ์ ํ์กํ ๊ฒ์ฌ ํ์.
| ํ์กํ | |
|---|---|
| ๊ฐ | - ์ ์ด๋ 12๊ฐ ์ด์์ ํ์กํ์ด ์์ผ๋, ์ฃผ๋ก ๋ํ๋๋ ๊ฒ์ 9๊ฐ์ง. - DEA(Dog erythrocyte antigen)์ผ๋ก ๋ํ๋ด๋ฉฐ, DEA 1.1๊ณผ 1.2๊ฐ ๊ฐ์ฅ ๋ง๋ค. - Antigen์ ๊ฐ์ง = Positive(+) : universal recipients (๊ฐ์ฅ ํํ ๊ฒ DEA 1.1+) - Antigen์ ๊ฐ์ง์ง ์์ = Negative(-) : universal donors (DEA 1.1-, 1.2-) - ์ต์ด ์ํ ์์๋ ํฌ๊ฒ ๋ฌธ์ ๋์ง ์์ผ๋, ๊ทธ ์ดํ๋ก๋ ๊ผญ ํ์กํ ๊ฒ์ฌ ํ ์ํ. |
| ๊ณ ์์ด | - AB system์ผ๋ก ๋ถ๋ฅํ๋ค: Type A, B, AB. - ๋๋ถ๋ถ์ ๊ณ ์์ด์์ type A๊ฐ ๊ฐ์ฅ ๋ง๋ค. (๊ฑฐ์ ๋ชจ๋ ํ์ข ์์) - Type๋ณ๋ก RBC์ ํญ์ฒด๋ plasma์ ํญ์ ์์์ ์ฐจ์ด๊ฐ ๋๋ค. ![]() - Group A๋ anti-B๋ฅผ ๊ฐ์ง๊ธด ํ์ง๋ง ๊ฑฐ์ ์๋ ํธ์ด๋ค. - Group B๋ anti-A๋ฅผ ์๋นํ ๋ง์ด ๊ฐ์ง๋ค. ๋ฐ๋ผ์ Group B์๋ง ์ํ ๊ฐ๋ฅํ๋ค. |
Analytic Principles and Methods
โ . Erythrogram
| Erythrogram ํ๊ฐ ํญ๋ชฉ | |
|---|---|
| 1. Morphologic evaluation | - ์ ํ๊ตฌ๋ morphology ๋ํ ์ค์ํ ์์์ ์ง๋จ ์์. - ๋น์ ์ color, size, ๋ชจ์, inclusion ์ฌ๋ถ ๋ฑ |
| ex) - Hgb ๊ฐ์ โ paleํ ์ผ์์ฑ, central pallor ํ๋ - Poikilocytosis(๋ณํ์ ํ๊ตฌ์ฆ๊ฐ์ฆ) - ๊ฐ์ผ โ ๋ณ์์ฒด์ inclusion | |
| 2. HCT (=PCV) | - ์ ์ฒด blood volume ์ค RBC๊ฐ ์ฐจ์งํ๋ ๋น์จ |
| 3. Blood [Hgb] | - ํ์ก 100ml๋น Hgb ๋๋. - [RBC] ๊ฐ์ํ๋ฉด ํ์ค [Hgb]๋ ๊ฐ์ํจ. |
| 4. [RBC] | - ์ ์ฒด blood volume ์ค RBC์ ๊ฐ์. RBC์ absoulte count. |
| 5. Wintrobeโs RBC indices | - ๋นํ์ ์ข ๋ฅ๋ฅผ ๊ตฌ๋ถํ๊ธฐ ์ํด ์ ์ฉํ ์์น. |
| - MCV | Mean cell volume. (RBC์ ํ๊ท ํฌ๊ธฐ) |
| - MCHC | Mean corpuscular Hgb concentration. (ํ๊ตฌ๋น ํค๋ชจ๊ธ๋ก๋น์ ๋๋) |
| - MCH | Mean corpuscular Hgb. (ํ๊ตฌ๋น ํค๋ชจ๊ธ๋ก๋น์ ์) |
| ex) - MCV ๊ฐ์ = RBC๊ฐ ๋ง์ด ๋ถ์ด = Hgb ๋ถ์กฑ = ์ฒ ๊ฒฐํ์ฑ ๋นํ | |
| - RDW | RBC์ ํฌ๊ธฐ ์ฐจ์ด๋ฅผ ๋ํ๋ด๋ ๊ฐ. (RBC volume variation) - ํ์ค ํธ์ฐจ์ ์ฐจ์ด๋ฅผ ๋ฐ์ : standard deviation of MCV รท MCV) ร 100 |
![]() - Macrocytic : rouleaux, reticulocytosis ๋ฑ (์ฌ์์ฑ ๋นํ ์์ฌ) - Microcytic : [Hgb] ๋ฎ์์ ๊ณ์ ๋ถ์ด (์ฒ ๊ฒฐํ์ฑ ๋นํ ์์ฌ) - ์ธํฌ ํฌ๊ธฐ๊ฐ ์ปค์ง๋ ์์์ง๋ ๋ค RDW๋ ์ฆ๊ฐ. | |
| 6. nRBCs | - WBC correction ํ์. - 5 nRBCs / 100 WBCs ์ด์์ด๋ฉด total WBC count์ ์ํฅ์ ๋ฏธ์นจ. - Corrected WBC count = WBC ร 100 / (nRBC+100) |
| 7. Reticulocytes | - correction ํ์ (corrected RP = absolute reticulocytes) - Reticulocytes๋ ๋์ผํ๋ฐ HCT ๊ฐ์ํ๋ฉด โ RP๋ ์๋์ ์ผ๋ก ์ฆ๊ฐ. โ ํ์์ reticulocytosis๋ฅผ ํ๋จํ ๋๋ CRP(corrected)๋ฅผ ๊ธฐ์ค์ผ๋ก. - ๊ณ ์์ด๋ ๊ฐ์ ๋ฌ๋ฆฌ aggregate form๊ณผ punctate form - blood loss(EPO ์๊ทน) ํ 3-4์ผ ๋ค์ reticulocytosis ๋ํ๋จ. |
โ ก. Methods
- RBC๋ ๋ง์ฐฌ๊ฐ์ง๋ก CBC์์ ๊ตฌํด์ง๊ธฐ ๋๋ฌธ์ WBC์ ๊ฑฐ์ ๋์ผํ ๋ฐฉ๋ฒ์ ์ด์ฉํ๋ค.
- Microhematocrit
- Impedance cell counters
- Laser flow cell cytometers
(1) Microhematocrit
- 13,000rpm์ high-speed centrifuge๊ฐ ํ์ํ๋ค.
- ETDA, heparin tube์์๋ 3,000rpm 10๋ถ์ด์๊ณ , Urine์ด๋ ๋ค๋ฅธ fluid์์๋ ๋ ๋ค๋ฅด๋ค.
- Centrifuge์ ์๊ฐ๊ณผ ๊ฐ๋๋ ์ธํฌ๊ฐ ์ผ๋ง๋ ํฌํจ๋์ด ์๋์ง์ ๋ฐ๋ผ ๋ฌ๋ผ์ง๋ค.
- Buffy coat : centrifuge ํ RBC ๋ถ๋ถ ๋ฐ๋ก ์์ ๋ ์๋ ์ธต.
- WBC์ platelet์ ํฌํจํ๋ค.
- ์ ์ฒด ํ์ก volume์ 0.5~1%๋ฅผ ์ฐจ์งํ๋ค.
- buffy coat ์ธต์ ํฌํจ๋ platelets๋ก PRP(platelet rich plasma)๋ฅผ ์ฑ์ทจํ๊ธฐ๋ ํ๋ค. (์ธ์, ์์์์ ์น๋ฃ ๋ชฉ์ ์ผ๋ก ๋ง์ด ์ด์ฉ๋จ. ์๋ฅผ ๋ค๋ฉด ํ๋ชจ ์น๋ฃ๋ผ๋ ๊ฐ..)
(2) Impedance cell counters
- ์ ๊ธฐ ์ ํญ ์๋ฆฌ๋ก ์ธก์ ํ๋ ๋ฐฉ๋ฒ.
- Large platelet๊ณผ small RBC๋ฅผ ์ ํํ๊ฒ ๊ตฌ๋ถํ์ง ๋ชปํ๊ธฐ ๋๋ฌธ์, ๊ฒฐ๊ณผ๊ฐ ๋ถ์ ํํ ์ ์๋ค.
- Large platelet ๊ด์ฐฐ = platelet์ ์์ฑ์ด ์ฆ๊ฐํ๋ค = ์ฆ platelet์ด ํ์ํ ์ถํ ์๊ฒฌ์ด ์์์ ์๋ฏธ.
- Small erythrocyte ๊ด์ฐฐ = hemoglobin์ด ๋ถ์กฑํ์ฌ mitoses๊ฐ ๊ณ์ ์ผ์ด๋๋ค = ์ฆ, ์ฒ ๊ฒฐํ์ฑ ๋นํ์ ์ผ์ผํฌ ์ ์๋ ์ง์์ ์ธ ์ถํ์ด ์์์ ์๋ฏธ.
- ์ด๋ฐ ์ํ์์๋ ๊ฒฐ๊ณผ ํด์์ ์ฃผ์ํ ๊ฒ.
- ๊ณ ์์ด ํ์ก์ ๊ฒฝ์ฐ RBC์ platelet์ด ๋ ๋ค ์์ ๊ตฌ๋ถ์ด ์ด๋ ต๊ธฐ ๋๋ฌธ์ ์ญ์ ๊ฒฐ๊ณผ๊ฐ ๋ถ์ ํํ๋ค.
(3) Laser flow cell cytometers
- ๋ค์ํ ์ฅ์ ๋ค์ ๊ฐ์ง๋ฉฐ, Wintrobeโs erythrocyte indices๋ฅผ ๊ตฌํ๊ธฐ ์ข๋ค.
โถ๏ธ Cytogram ๋ถ์๐
Morphologic Features of Erythrocytes: Clinical Significance and Pathogeneses
โ . Assessment
- ์ ํ๊ตฌ์์๋ ๋นํ์ ์ง๋จ ๋ฐ ์ข ๋ฅ ๊ตฌ๋ถ์ ์ํด morphology ํ๊ฐ๊ฐ ๋งค์ฐ ์ค์ํ๋ค.
- ์ธํฌ์ ํฌ๊ธฐ, ๋ชจ์, ์๊น ๋ฑ ๋น์ ์ ์๊ฒฌ์ ํ๊ฐํ๋ฉด ๋๋ค. ๋๋ฌผ๋ ์ฆ 100๋ฐฐ ํฌ๊ธฐ์์ ์ถฉ๋ถํ ๊ด์ฐฐ ๊ฐ๋ฅํ๋ค.
- poikilocytes์ ์ฌ๊ฐ๋๋ 3-plus scale (
1+~3+) ๋๋ 4-plus scale (1+~4+) ๋ก ๋ํ๋ธ๋ค. (ex. 1+ polychromasia)- ์ง์ ์ ์ํด๋ ๋จ. (ex. โ1+ grade = 6 poikilocytes/300RBC๋ก ํ์ํ๋ค.โ)p
โ ก. General Features
Mature RBC = Discocytes (์ ์ ์ ํ๊ตฌ)

- biconcavity ํํ, ๊ฐ์ด๋ฐ๊ฐ ์ํน ๋ค์ด๊ฐ ์๋ค.
- diff-quick staining์์ ๊ฐ์ด๋ฐ ๋ถ๋ถ์ด ์ผ์๋์ง ์์ ์ฐฝ๋ฐฑํ โcentral pallorโ๋ก ๋ํ๋๋ค. (๊ฐ)
- โNormocytesโ๋ผ๋ ํํ์ โ์ ์์ ์ธ cell volume์ ๊ฐ์ง ์ธํฌโ + โ์ ์์ ์ธ Hgb ์์ ๊ฐ์ง ์ธํฌโ๊น์ง ํฌํจํ๋ ์๋ฏธ๋ฅผ ๊ฐ์ง๋ค.
Rouleaux formation or Agglutination
Rouleaux
- ์ ํ๊ตฌ์ aggregation์ผ๋ก ์ธํด coin ํํ๋ก stacking๋ ๊ฒ.
- ๋ง๊ณผ ๊ณ ์์ด์์๋ ์ ์์ ์ผ๋ก ํํ ๊ด์ฐฐ๋๋ค.
- (1) Albumin factors, (2) globulin factors, (3) lipid ๋๋๊ฐ ๋์์ ์๊ธด ์ธํฌ ์ฌ์ด์ ์ ๊ธฐ์ ๊ฒฐํฉ์ด ์์ธ. Plasma protein ๋๋์ ์ํฅ์ผ ๋๊ฐ ๋ง๋ค.
- Hyperglobulinemia, hyperfibrinogenemia๊ฐ ์์ ๋ ๊ฐ์ฅ ํํ๊ฒ ๋ณด์ธ๋ค. : ์ผ์ฆ์ฑ leukogram (cell membrane lipid ๋ณํ๋ก ์ธํด)
- ์ธํฌ๋ค์ด ์ ๋นํ ๊ฐ๊ฒฉ์ ๋๊ณ ๋ถํฌํ๋ feathered edge ๋ถ๋ถ์์๋ plasma protein ๋๋๊ฐ ๋์ผ๋ฉด ๊ด์ฐฐ๋๋ค.
Agglutination
- RBC clotting โ ํฌ๋์ก์ด ๋ชจ์์ cluster๋ฅผ ํ์ฑํ ๊ฒ.
- Cold agglutination์ ์ํด ๋ํ๋๋ค.
- ๋๋ถ๋ถ immune-mediated๋ก ๋ฐ์ํด IMHA์์ ๊ฐ์ฅ ํํ๋ค.
Saline dilution : Rouleaux์ Agglutination ๊ตฌ๋ถ
- ๋ชจ์๋ง ๋ณด๊ณ ๊ตฌ๋ถํ๊ธฐ๋ ์ฝ์ง ์๋ค.
- saline๊ณผ ํฌ์ํ๋ฉด plasma protein ๋๋๊ฐ ๋ฎ์์ ธ rouleaux๋ ๋ณดํต ํ์ด์ง๋ค.
- ๋ฐฉ๋ฒ
- Blood์ saline์ 1:1๋ก ์์ด์ ํฌ์ํ๋ฉด ๋๋ถ๋ถ์ rouleaux formation์์๋ ํ์ด์ง.
- ์ฌํ ๊ฒฝ์ฐ์๋ 1)๋ก ๋ถ์ฐ๋์ง ์์ผ๋, 1:4 dilution๊น์ง ํด๋ณด๋ฉด ์ด๋ ์๊ฐ ๋ถ์ฐ๋จ.
Rubricytosis

- Rubricytes : reticulocyte ์ ๋จ๊ณ์ ๋ชจ๋ nRBCs๋ฅผ ๋งํ๋ค.
- ์์์ ์ผ๋ก๋ ๋ณดํต ๋ฐ๋ก ์ ๋จ๊ณ์ธ metarubricytes๋ฅผ ์๋ฏธ.
- Rubricytosis๋ nRBC count์ ์ฆ๊ฐ๋ฅผ ์๋ฏธํ๋ฉฐ, ์ฌ์์ฑ ๋นํ์์ ํํ ๊ด์ฐฐ๋๋ ์๊ฒฌ์ด๋ค.
- ์ฆ, ๊ณจ์์ ์ฌ์์ฑ ๋ฐ์์ด ์๋ ๋นํ์์ reticulocytosis๋ฟ๋ง ์๋๋ผ nRBC๊ฐ ์๋ rubricytosis๋ ๊ด์ฐฐ๋ ์ ์๋ค.
- Erythropoiesis๊ฐ ๋์ฑ ํ๋ฐํ ๋ํ๋๊ณ ์์(๊ฐ์๋๊ณ ์์)์ ์๋ฏธํ๋ค.
Appropriate / Inappropriate rubricytosis
- Appropriate rubricytosis : Reticulocytosis๋ฅผ ๋๋ฐํจ.
- ๋นํ์ ๋ํ ๋ฐ์์ผ๋ก ๋ํ๋๋ ์ ํฉํ ์ ์ฒด์ ์ฌ์์ฑ ๋ฐ์.
- ๋นํ โ EPO ์๊ทน โ nRBC ์์ฑ โ Reticulocytes, Rubricytosis
- Inappropriate rubricytosis : ์ ์์ ์ธ ๊ณผ์ ์ด ์๋๋ผ, Reticulocytosis๋ฅผ ๋๋ฐํ์ง ์์.
- Erythropoiesis ๊ณผ์ ์ ์ด์์ผ๋ก nRBC(metarubricytes)๊ฐ ๊ณจ์์์ ๋ง์ดํ๋ก ๋ฐ๋ก ๋ฐฉ์ถ๋จ.
Inappropriate rubricytosis์ ์์ธ
- ์ฃผ๋ก Bone marrow์ ๋ฌธ์ ๊ฐ ์๊ฒจ ๋ฐ์ํจ.
- Extramedullary hematopoiesis, splenic contraction์ผ๋ก ์ธํด nRBCs ๊ด์ฐฐ.
(Erythropoiesis ๊ณผ์ ์ ๋ค ๊ฑฐ์น์ง ๋ชปํด nRBC์ธ ์ฑ๋ก spleen์ด๋ ๋ง์ด ํ์ก์ ์กด์ฌ)- Splenectomy ์ดํ ์ผ์ ๊ธฐ๊ฐ nRBC๊ฐ ๊ด์ฐฐ๋ ์ ์์.
- Lead poisoning(๋ฉ ์ค๋ ์ฆ)์ผ ๋ bone marrow ์์์ ์ ๋ฐํ ์ ์์.
- Poodle์์ ๋ํ๋๋ bone marrow dyscrasia : macrocytosis์ nRBC๊ฐ ๊ณจ์์ ๋ง์ดํ์์ ๋๋๋ฌ์ง๊ฒ ๊ด์ฐฐ๋๋ ํ์ข ํน์ด์ ์ ์ ์ฑ ์งํ.
โ ข. RBC Color
| Central pallor | - Central pallor ํ์ฅ โ ์ผ์๋๋ ๋ถ๋ถ์ด ๊ฐ์, ์ฆ Hgb ์์ด ์ ๋ค๋ ์๋ฏธ. (โhypochromasiaโ) - Central pallor ๊ฐ์ โ RBC ๋ชจ์์ ์ด์์ด ์๊ธธ ๋(poikilocytes) ์์ฃผ ๋ณด์ธ๋ค. |
Spherocytes![]() | - ํฌ๊ธฐ๊ฐ ์๊ณ , central pallor๊ฐ ๊ฐ์ํ ํํ. ์ง๊ฒฝ ๋๋น Hgb ๋๋๊ฐ ๋์. - Macrophage์ partial phagocytosis์ ์ํด ๋ํ๋๋ค. (= macrophage์ ์์ ํ ํ์๋์ง ๋ชปํจ = ํ์์ด ๊ฐ์ํจ) - RBC๊ฐ ํฌ๊ณ central pallor๊ฐ ๋ช ํํ ๊ฐ์์ ์ฝ๊ฒ ๊ตฌ๋ถ๋์ง๋ง, ๊ณ ์์ด์์๋ ์ ๊ตฌ๋ถ๋์ง ์๋๋ค. - Fragmentation์ด ์ฝ๊ฒ ์ผ์ด๋ hemolytic anemia๋ฅผ ์ ๋ฐํ๋ค. (IMHA์ ๊ด๋ จํด์ ํน์ง์ ์ผ๋ก ๊ด์ฐฐ๋๋ค.) |
Ghost cell![]() | - Hgb ์์ด ์์ฃผ ์ ๊ฒ ๋จ์ ๋งค์ฐ ์ฐฝ๋ฐฑํ๊ฒ ๊ด์ฐฐ๋๋ ์ ํ๊ตฌ. - ์ฉํ์ด ์ฌํด ์ธํฌ๋ง์ ํตํด Hgb์ด ์ ์ถ, ์ผ์์ฑ์ด ๋ฎ์์ง๋ค. - ๋ณด์ฒด ๋งค๊ฐ์ฑ ํ๊ด๋ด ์ฉํ์ฑ ๋นํ์์ ๊ด์ฐฐ๋๋ค. |
| Hypochromic RBC | - Hgb ์์ด ๊ฐ์ํด central pallar๊ฐ ํ๋๋ ์ ํ๊ตฌ. |
| Polychromatophilic erythrocyte | - Reticulocyte๊ฐ diff-quick์ด๋ wright-giemsa ์ผ์์์ ๊ด์ฐฐ๋๋ ๋ชจ์ต. |
๋จ๋ด_Spherocytes (๊ตฌ์์ ํ๊ตฌ)
- ํญ์ฒด๋ก ์ฝํ ๋ ์ ํ๊ตฌ๋ง ์ผ๋ถ๊ฐ ํ์๋์ด, ํฌ๊ธฐ๊ฐ ์์์ง๊ณ ์ฐฝ๋ฐฑํ ์ค์๋ถ๊ฐ ์์ค๋ ์ ํ๊ตฌ ํํ
โ loss of the normal discoid shape, decreased size, loss of central pallor- ๊ณผ์ : Mononuclear-phagocytic cells๊ฐ ์ ํ๊ตฌ์ ํญ์์ ๋ถ์ฐฉ, Fc receptor์ ๊ฒฐํฉ โ ์ธํฌ์ง๊ณผ ๋ง์ด ๋ฏ๊ฒจ์ง(โbites offโ) โ ๋จ์ ์ ๋ค๋ผ๋ฆฌ ๋ญ์ณ์ ๋ ์๊ณ , central pallor๊ฐ ์๋ spherocyte ํ์ฑ
- ๋ฉด์ญ ์ฉํ ๋นํ๋ฟ๋ง ์๋๋ผ Babesia gibsoni ๊ฐ์ผ, ์์ฐ ๋ ์ฑ, hemophagocytic malignant histiocytosis, ๋ณด๊ดํ ์ง ์ค๋๋ ํผ๋ฅผ ์ํํ์ ๋๋ ๋ํ๋ ์ ์๋ ํน์ง.
- ๊ฐ : ์ฃผ๋ก immune hemolysis์ ์ํด
- ๊ณ ์์ด: ๋ฉด์ญ๋ณด๋ค๋ Drug-associated hemolysis(ฮฒ-lactam ํญ์์ ์๋ชป ๋จน์์ ๋), mycoplasmosis + IHA ๋ฑ์ ์ํด ๋ํ๋ ๋๊ฐ ๋ง์
- ์ ์ ์ ํ๊ตฌ๋ณด๋ค ๋จ๋จ(more rigid), ์ ๋ณํ๋์ง ์์(less deformable), ๋น์ฅ์ ํต๊ณผํ๋ฉด์ ์ ๊ฑฐ๋จ.
โ ฃ. RBC Organisms
Table 3.5 Erythrocyte organisms
- Anaplasma, Babesia ๋ฑ์ pathogen๋ค์ด RBC ๋ด์์ inclusion ํํ๋ก ๊ด์ฐฐ๋๋ค.
- pathogen์ ์ข ๋ฅ์ ๋ฐ๋ผ ๋ชจ์์ ๋ค๋ฅด๋ค.
- Morphology๋ง์ผ๋ก ํ์ง์ ์ด๋ ค์ฐ๋, ์์ ์ฆ์๊ณผ PCR๋ก ํ์งํ ์ ์๋ค.
โ ค. RBC Inclusions (other than organisms)
Pathogen ์ธ์ ์์ธ์ผ๋ก ๋ํ๋๋ inclusion.
Table 3.6 Erythrocyte inclusions other than organisms
| ์ด 3๊ฐ ์ ๋๋ ์์! | |
|---|---|
Howell-Jolly body![]() | - RBC ๋ด๋ถ์ ํต์ ์์ฌ๋ฌผ์ด ๋จ์ - Erythropoiesis๊ฐ ํ๋ฐํ ๋ ๊ด์ฐฐ๋จ. (๊ทธ๋ฌ๋ ๊ฑด๊ฐํ ํฌ์ ๋ฅ์์๋ ์ข ์ข ๊ด์ฐฐ๋ ์ ์์ผ๋ฉฐ, ํนํ ๊ณ ์์ด์์ ๋น๋ฒํ๊ฒ ๊ด์ฐฐ.) |
Basophilic stippling (ํฐ ํ์ดํ)![]() | - RNA ์์ฌ๋ฌผ์ด ๋จ์ ๋ ์์ dark-purple dots๊ฐ ๊ด์ฐฐ๋จ. - ์ญ์ RBC ์์ฑ์ด ํ๋ฐํด์ ๋ํ๋ด๋ ํํ. |
Heinz body![]() ![]() ![]() (์ผ: pale staining โ ๊ฐ์ฅ์๋ฆฌ ๋ ์๊ฐ ๊ฒ์ฒ๋ผ ๋ณด์ / ์ค: NMB์์ blue color) | - ์ฐํ ์ผ์์ฑ(slightly pale)์ ๋๊ทธ๋ ๊ตฌ์กฐ๋ฌผ์ด ๋ง์ ๋ถ์ฐฉ๋ ํํ. - ์ฐํ์ ์์์ ์ํด ๋ณ์ฑ๋ Hgb๊ฐ ์ธํฌ๋ง์ ์ถ์ ๋์ด ๋ํ๋จ. - ์ฐํ์ ์์์ ์์ธ์ผ๋ก๋ acetaminophen ์ค๋ , ์ํ ์ค๋ , ์ฝ๋ฌผ ๋ฑ์ด ์์. - Diff-quik์์๋ paleํ ์ผ์์ฑ / NMB์์๋ blue color๋ก ๋ํ๋จ. - ๋ณ์ฑ๋ Hgb์ด ์ถ์ ๋์ด cell membrane์ด ์ ์ฝํด์ง๊ธฐ ๋๋ฌธ์ ์ฝ๊ฒ ์ฉํด๋ ์ ์์. โ Heinz body๊ฐ ๋ณด์ด๋ฉด Hemolytic anemia์ธ ๊ฒ์ ์๋ฏธ. |
โ ฅ. Abnormal Erythrocyte Volume
- Anisocytosis : RBC volume์ ๋น์ ์์ ์ธ variation
- Macrocytosis๋ microcytosis (or both) ๊ฐ ๊ด์ฐฐ๋จ
- Macrocytic = MCV ์ฆ๊ฐ
- Poodle์ inappropriate rubricotysis์์ macrocytosis๋ ๊ฐ์ด ๊ด์ฐฐ๋ ์ ์์.
- Reticulocytes๋ macrocyticํ ์ธํฌ.
- Microcytic = MCV ๊ฐ์
- ์ฒ ๊ฒฐํ์ฑ ๋นํ(3๊ฐ์ ์ฝํผ ํ๋ ธ๋ ์ผ์ด์ค) : ์ง์์ ์ถํ, ์ฌ์์ฑ ๋ฐ์ ์ ๊ณ microcytic
- ์ฒ ๊ฒฐํ๋ฟ๋ง ์๋๋ผ ๊ฐ ์งํ(portosystemic shunts), ๊ตฌ๋ฆฌ ๊ฒฐํ ๋ฑ์์๋ ๋ํ๋จ.
- ํน์ ํ์ข ์์ ์ ์์ ์ผ๋ก RBC๊ฐ ์๊ฒ(microcytic) ๊ด์ฐฐ๋จ. (Akitas, Shibas, Jindos, chow-chows, shar-peis)
- Spherocyte๋ ๋ถํผ, ์ง๊ฒฝ ๊ฐ์๋ microcyte์ ํ ์ข ๋ฅ. (Macrophage์ ์ํด partial phagocyte๋์ด ์ง๊ฒฝ๋ ๊ฐ์.)
โ ฆ. Abnormal Erythrocyte Shape
Artifact๋ก ๊ด์ฐฐ๋ ์ ์๋ ๊ฒ๋ค, morphology ํ๊ฐ ์ ์ฃผ์.
| Poikilocytes | |
|---|---|
Acanthocytes (Spur cell)![]() | - ๋ถ๊ท์นํ ํํ์ spicules(๋๊ธฐ) ๊ด์ฐฐ. - Cholesterol ์์ ๋ณํ๋ก ์ธํฌ๋ง์ phospholipid ์ธต์ ๋ณํ๊ฐ ์๊น. - Splenic and hepatic diseases, splenic hemangiosarcoma : ๋น์ฅ, ๊ฐ ์งํ ๊ด๋ จํด์๋ ๋ํ๋ ์ ์์. - Microangiopathy : chemical injury์ ์ํด ๋น์ฅ์ ์ ์ ํ๊ด ํฌ๊ธฐ์ ๋นํด ํ๊ด ๋ด๊ฐ์ด ์ข์์ง๋ ์งํ. |
Target cells, Codocytes![]() | - central pallor๊ฐ ์๋ก ์์์, ์ง์ง ๊ณผ๋
๋ชจ์์ผ๋ก ๊ด์ฐฐ๋จ. - ์์ธ ; Hgb ๋๋ ๊ฐ์, ๊ฐ ์งํ, splenectomy ์ดํ, ์ฒ ๊ฒฐํ(๋นํ) ![]() |
Dacrocyte (Tear-drop cell)![]() | - Tear drop cell, tennis racket cell. ๊ผฌ๋ฆฌ๋ฅผ ๊ฐ์ง ๊ฒ์ฒ๋ผ ๋ํ๋จ. - ๋๋ฌผ์์๋ ๋๋ฌผ๊ณ , ์ฌ๋์์๋ ์ฌ๊ฐํ ๋นํ ์งํ๋ก์ ์์์ ์์๊ฐ ์์. |
Mycoplasma haemofelis![]() | - Howell Jolly์ ๋น์ทํ๋, - cytoplasm ๋ด์ธก์ ์กด์ฌํ๋ Howell-Jolly์ ๋ฌ๋ฆฌ Mycoplasma haemofelis๋ cell membrane์ ๊ฐ๊น๊ฒ ์์นํ๊ณ , 400๋ฐฐ์์ ๋ณด๋ฉด ํต ์์ฌ๋ฌผ๊ณผ ๋ฌ๋ฆฌ ์์ roundํ ํํ๊ฐ ์๋. - PCR ์ง๋จ ํ์. |
Echinocyte![]() | - RBC fragment์ฒ๋ผ ๋ณด์ด๋ ๋ถ๊ท์นํ spicule์ ๊ฐ์ง๊ณ ์์. |
Stomatocyte![]() | - RBC ์ฌ์ด slit์ด ์์. - ๊ฐ์์ ํ์ข ์์ธ์ ์ํด ์ ์ ์ฑ์ผ๋ก ๊ด์ฐฐ๋๊ธฐ๋ ํจ. |
Schizocyte![]() | - RBC fragment์ ํ๋. Acanthocytes์ ์ ์ฌํ๊ฒ ์๊น. - Intravascular coagulation์ด๋, vasculitis์ ์ํด ํ๊ด ๋ด๊ฐ์ด ์ข์์ ธ ํ๋ฅ ์๋์ ๋ณํ๊ฐ ์๊ธฐ๋ฉด์ ๋ฐ์. |
Anemia
โ . General information
- ๋นํ : [RBC] ๊ฐ์, [Hgb] ๊ฐ์, Hct ๊ฐ์ํ Pathologic state (๋ณ๋ฆฌ์ ์ํ)
- ํ์ก ๊ฐ์ โ RBC loss ์ฆ๊ฐ
- RBC ํ๊ดด ์ฆ๊ฐ
- ๊ณจ์์์ RBC ์์ฐ ์ ํ (EPO ์์ฐ ๋ฌธ์ ๋ฑ)
- ์์ ์๊ฒฌ : Exercise tolerance ๊ฐ์, Weakness, Depression, Tachypnea(๋นํธํก)
- ํ์ค O2๊ฐ ๋ถ์กฑํ๊ธฐ ๋๋ฌธ
- ์ ์ฒด ๊ฒ์ฌ ์๊ฒฌ : ์ฐฝ๋ฐฑํ mucous membrane color (์๋ชธ, ๊ฒฐ๋ง, ์ง ๋ฑ)
- ๋ง์ด ํ๊ด์ ํ์ก์ด ๋ถ์กฑํ๊ธฐ ๋๋ฌธ
- ์ฌ๊ฐํ ๋นํ์์๋ ์ฌ์ก์ (systolic heart murmur)
โ ก. Classifications of anemias
โบ๏ธ Bone marrow์ ๋ฐ์์ฑ
- Reticulocytosis ๊ด์ฐฐ ์ฌ๋ถ์ ๋ฐ๋ผ ์ฌ์์ฑ/๋น์ฌ์์ฑ์ผ๋ก ๊ตฌ๋ถ๋จ.
| Regenerative anemia (์ฌ์์ฑ ๋นํ) | Nonregenerative anemia (๋น์ฌ์์ฑ ๋นํ) |
|---|---|
| ํ์ก ์์ค์ด๋ ์ฉํ์ ๋ํ ๋ฐ์์ผ๋ก ๋ํ๋จ. | ๊ณจ์์ ๋ฐ์์ฑ์ด ์์ด์ง๊ฑฐ๋, RBC ์์ฑ์ ๋ฌธ์ ๊ฐ ์๊ฒจ ๋ํ๋จ. RBC precursor cell์ด ์์์ ๋ฐ๋ ๊ฒฝ์ฐ. |
| Reticulocytosis ๊ด์ฐฐ๋จ. (RC โ, CRP โ, polychromasia โ) Rubricytosis์ ๋๋ฐ๋๊ธฐ๋ ํจ. (nRBC ๊ด์ฐฐ) | Production์ ๋ฌธ์ ์ผ ๋ฟ ์กด์ฌํ๋ RBC์๋ ์ํฅ์ด ์์ผ๋ฏ๋ก Normocytic, Normochromic anemia. |
| Macrocytic hypochromic, anisocytosis (RDW ์ฆ๊ฐ), Howell-Jolly bodies, codocytes(target cell), basophilic stippling ๊ด์ฐฐ | ์ฃผ๋ก ๊ณจ์์ ๋ฌธ์ โ Erythroid hypoplasia, marrow aplasia, red cell aplasia, myelofibrosis, myelitis, myelophthisis, ineffecitve erythropoiesis |
๋น์ฌ์์ฑ ๋นํ์ ์ผ์ผํฌ ์ ์๋ ์์ธ
Reduced erythropoiesis
- ์ผ์ฆ์ฑ ์งํ (primarily chronic)
- ๊ฐ์ผ์ฑ (bacterial, fungal, viral, protozoal, parasitic
- ๋น๊ฐ์ผ์ฑ
- ์ ์ฅ ์งํ (chronic) : ์ ์ฅ ์ค์ง ์ธํฌ๊ฐ ์ฌ์ ํ (renal fibrosis) โ Epo ์์ฑ ๋ถ๊ฐ
- Bone marrow hypo/aplasia ์ ๋ฐ ์งํ
- ๊ฐ์ผ์ (bacterial, fungal, viral, protozoal)
- Toxicosis (chemotherapeutic agents, estrogen, bracken fern, phenylbutazone)
- Irradiation (whole body or environmental)
- ๊ณจ์ ์ข ์ or replacement (neoplasia, myelofibrosis, osteopetrosis)
- Selective erythroid hypo/aplasia ์ ๋ฐ ์งํ
- PRCA (pure red cell aplasia)
- FeLV-induced erythroid hypoplasia
- ๋ด๋ถ๋น (hypothyroidism, hypoadrenocorticism, hypoandrogenism, hyperestrogenism
- ๊ฐ ์งํ, ๊ฐ ๋ถ์ (PSS; portosystemic shunts ํฌํจ)
Ineffective erythropoiesis
- Nutritional : Fe, Cu, Cobalt, Folate, Vitamin B12 deficiency
- Immune-mediated nonregenerative anemia
- Dyserythropoiesis of English springer spaniels
- Congenital dyserythropoieses of polled Hereford calves
โบ๏ธ RBC indices์ ๋ฐ๋ฅธ ์ธํฌ์ mophologic classification
| MCV (RBC ํฌ๊ธฐ) | MCHC (Hgb ์) | |
|---|---|---|
| Normocytic | Normochromic | ๋นํ์ธ๋ฐ Normo, Normo : ๋น์ฌ์์ฑ ๋นํ์ ๊ฐ์ฅ ์ ํ์ ์ธ ํน์ง. (์์ฑ์ด ๊ฐ์ํ ๋ฟ, ๋ฏธ์ฑ์ RBC๊ฐ ๋ฐฉ์ถ๋๋ ๊ฒ X) |
| Macrocytic | Hypochromic Normochromic | Macrocytic โ Reticulocytosis (hypochromic, normochromic ๋ ๋ค) |
| Microcytic | Hypochromic Normochromic | ์ธํฌ์ ํฌ๊ธฐ๊ฐ ์์์ง ๊ฒ์ ์ฒ ๊ฒฐํ์ฑ ๋นํ์ ์์ฌํจ. (์ฒ ๊ฒฐํ โ Hgb ํฉ์ฑ ์ฅ์ โ Hgb ํฉ์ฑ์ ์์ฑ์ํค ๊ธฐ ์ํด mitosis๊ฐ ์ผ์ด๋ ์ธํฌ์ ํฌ๊ธฐ๊ฐ ์์์ง.) |
| Normocytic | Hypochromic | (์ค์ ๋ก ๊ฑฐ์ ๊ด์ฐฐ๋์ง ์๋๋ค๊ณ ํ๋, case ๋ถ์ํ๋ ๋ด์ฉ์ ๋ณด๋ฉด ์ด ๊ฒฝ์ฐ๋ Reticulocytosis ๊ณผ์ ์ค์ ์๋ค๊ณ ์๊ฐํ๋ฉด ๋ ๋ฏํจ) |
| - | Hyperchromic | ๊ฑฐ์ ๊ด์ฐฐ๋์ง ์์. ๊ฒ์ฌ ์ด์์ด ์์ฌ๋จ. |
โบ๏ธ Pathophysiologic classification
1) Blood loss์ ์ํ ๋นํ
| Acute blood loss | Chronic blood loss |
|---|---|
| ๋ช ์๊ฐ~๋ฉฐ์น ๋์ ๋ฐ์. | ์ ์ฃผ~์ ๊ฐ์ ์ฅ๊ธฐ๊ฐ ์ง์. |
| ๊ณจ์๊ฐ ๋ฐ์ํ์ฌ ์ฌ์์ฑ ๋นํ | ํนํ ์ฒ ๊ณ ๊ฐ๋ก ์ธํด ๊ณจ์์ ์ฌ์์ฑ ๊ธฐ๋ฅ์ด ๊ฐ์ํ๊ณ , ๋น์ฌ์์ฑ - ์ฒ ๊ฒฐํ์ฑ ๋นํ |
| External blood loss | Internal blood loss |
|---|---|
| ๋ชธ ๋ฐ์ผ๋ก ์ ์ถ๋๋ ์ผ๋ฐ์ ์ธ ์ถํ. ์ํ๊ณ๋ ๋น๋จ๊ณ๋ฅผ ํตํด ์ธ์ง ๊ฐ๋ฅํ ํ์คํ ์๊ฒฌ์ด ๋ํ๋จ. | ํ๊ด ๋ด์์ ํ๊ด ๋ฐ์ผ๋ก ์ด๋ํ๋ ์ถํ. ๋ณดํธ์๊ฐ ์ธ์งํ๊ธฐ ์ด๋ ค์ ๋ง์ฑ์ผ๋ก ์งํ๋ ๋๊ฐ ๋ง์. |
| ๋ํ์ ์ผ๋ก ๋ณต๊ฐ/ํ๊ฐ(peritoneal/pleural cavities)์ ํ์ก์ด ์ฐจ๋ ํ๋ณต์, ํํ์ |
2) Hemolytic anemia
| Extravascular hemolysis | Intravascular hemolysis |
|---|---|
| ํ๊ด ๋ฐ์์ ๋ํ๋จ. | ํ๊ด ๋ด์์ ๋ํ๋จ. |
| ์ฃผ๋ก splenic/hepatic macrophage์ ์ํจ. | ๋ํ์ ์ผ๋ก IMHA, heinz body anemia ๋ฑ. |
3) RBC ์์ฐ ๊ฐ์์ ์ํ anemia
- ์ผ์ฆ์ฑ ์งํ, ์ ์ฅ ์งํ, ๊ณจ์ ์ ํ์ฑ/๋ฌดํ์ฑ, erythroid ์ ํ์ฑ ๋ฑ (์ ๋น์ฌ์์ฑ ๋นํ ์์ธ ์ฐธ๊ณ )
โ ข. Erythrocyte kinetics
| Acute blood loss | Chronic blood loss |
|---|---|
| ๋นํ + Hypoproteinemia (๊ทธ๋์ TP ๋๋๋ก๋ blood loss ํ์ ๊ฐ๋ฅ) | ์ฒ ๊ฒฐํ์ฑ ๋นํ โ Micocytic hypochromic RBCs |
| ํ๊ด์์ RBCs & plasma protein ์์ค โ Hypovolemia ๋ฐ์ โ ECF๊ฐ ํ๊ด๋ด๋ก ์ด๋ํด ์ฑ์ โ ํ๊ด๋ด RBC๊ฐ ๋์ฑ ํฌ์ํ ๊ฒ์ผ๋ก ์ธ์ โ ๋น์ฅ์ด ์์ถํ์ฌ ์ ์ฅ๋ RBCs ๋ฐฉ์ถ | RBCs, plasma proteins, ์ฒ ์ด ๊ฐ์ด ์์ค (๊ณจ์์ erythropoiesis ๋ฐ์ ์์) โ ์ฅ๊ธฐ๊ฐ ์ง์๋๋ฉฐ ์ ์ฅ๋ ์ฒ ์ด ๊ณ ๊ฐ, ์ด๊ธฐ์ ๋นํด ๊ณจ์์ erythropoiesis ๊ฐ์ โ ์์ฒด๋ด ์ฒ ์ด ๊ณ ๊ฐ. ์ฒ ๊ฒฐํ์ฑ ๋นํ. |

Nonregenerative Anemias
โ . General concepts
โ ก. Disorders that cause nonregenerative anemias
Blood loss Anemias
โ . Causes of blood loss
โ ก. Classification based on duration and location
Hemolytic Anemias
โ . Concepts and classifications
โ ก. Hemolytic disorders and diseases
IMHA (Immune-mediated hemolytic anemia)
- ๊ฐ์ ๊ฐ์ฅ ํํ extravascular hemolysis ์์ธ.
- Spherocyte ํ์ฑ์ด ๊ฐ์ฅ ํฐ ํน์ง. RBC rupture๋ก ghost cell๋ ๊ด์ฐฐ๋๋ค.
- Ghost cell์ RBC ์์, ํนํ intravascular hemolysis์ ์ค์ํ ํน์ง์ด๋ค.
Spherocye๋ IMHA์ ์ฃผ์ ํน์ง, ghost cell์ intravascular hemolysis์ ์ฃผ์ ํน์ง!
TIBC
- Apotransferrine + Fe3+ ๊ฒฐํฉ